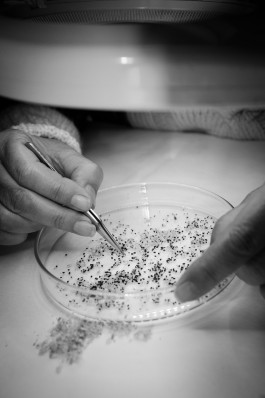

↓


Amir Kassaei // DIE ZEIT

Elfie Donnelly // DIE ZEIT








Waldschule Barcelona // Werde Magazin


Sandra // brand eins

Vicente Todolí


Iolanda Bustos // Werde Magazin


Terese Rodriguez // Werde Magazin


Amir Kassei // DIE ZEIT



Son Moragues // Werde Magazin


Jaume Pujol // DER SPIEGEL



Vicente Todolí



Sarah Boss // manager magazin


Markus Rieger-Ladich // brand eins


Triqbriq // brand eins


Kalk // Werde Magazin




Tobias Hertfelder // brand eins

Rewilding Spain // Werde Magazin




Elena Tretyakova // DER SPIEGEL



Marcus Witzke // brand eins

Gesexte Samen // brand eins


Juan Ferrer // DER SPIEGEL


Miriam Wohlfarth // manager magazin

Patrick Roetzl // DIE ZEIT




Heinz Georg Kramm // DER SPIEGEL
Jelena Bogdanić // Werde Magazin


Tilmann Oberle // brand eins


Vedran Horvat // Werde Magazin




Elfie Donnelly // DIE ZEIT


Gilles Clément // Werde Magazin

DER SPIEGEL
